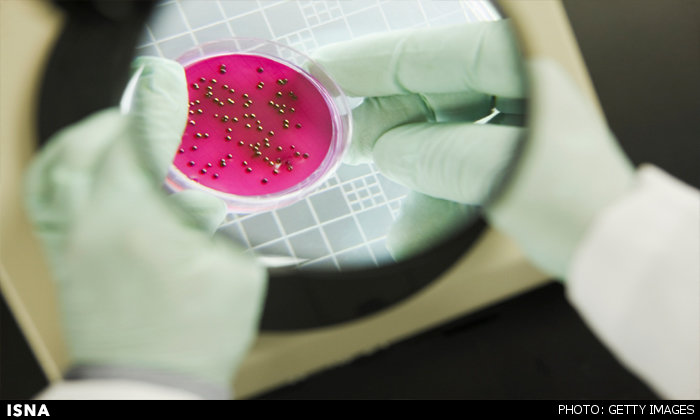
تشخیص فوری عفونت‌های باکتریایی با دستگاه جدید

تشخیص فوری عفونتهای باکتریایی با دستگاه جدید
محققان بیمارستان عمومی ماساچوست در آمریکا دستگاه جدیدی را تولید کرده اند که ممکن است زمان مورد نیاز برای تشخیص سریع عفونتهای باکتریایی را از چند روز به چند ساعت کاهش دهد.
این سیستم میتواند تشخیص سریع را ارائه کند زیرا به تاسیسات و تخصصی که تنها در آزمایشگاههای بیمارستانها موجود است، نیاز ندارد.
تشخیص سنتی مبتنی بر کشت اگرچه استاندارد طلایی برای شناسایی عفونتهای باکتریایی در نظر گرفته میشود، چندین روز به طول میانجامد و به تجهیزات پیچیده، کارکنان آموزشدیده آزمایشگاه و فرآیندهای مختلف - بسته به عامل بیماری – احتیاج دارد.
رویکردهای نوظهور ژنتیکی که گونههای باکتریایی را از روی توالی اسید نوکلئیک آنها شناسایی میکنند، قدرتمند هستند اما به تجهیزات پیچیده و کارکنان زیاد نیاز دارد که چنین آزمایشاتی را به آزمایشگاههای تخصصی بیمارستانی محدود میکند.
سیستم "تشخیص ناهمسانگردی قطبش" (PAD)، آزمایش ژنتیکی دقیق را با یک دستگاه ساده امکانپذیر میکند. آر.ان.ای باکتریایی از یک نمونه در یک کارتریج پلاستیکی یکبار مصرف کوچک استخراج میشود.
این ماده در پی تقویت واکنش زنجیره پلیمر از آر.ان.ای، در یک مکعب پلاستیکی دو سانتیمتری پر میشود که حاوی اجزای نوری با قابلیت شناسایی آر.ان.ای های هدف بر اساس واکنش به یک سیگنال نوری از کاوشگرهای تشخیص توالی خاص است.
این مکعبهای نوری بر روی یک ایستگاه الکترونیکی قرار داده میشود که دادهها را به تلفن همراه هوشمند یا رایانه برای نمایش نتایج ارسال میکنند.
برای این تحقیق، محققان از یک سیستم PAD پیش ساخته استفاده کردند که حاوی چهار مکعب نوری برای آزمایش نمونههای بالینی 9 بیمار و مقایسه نتایج با نمونههای بدست آمده توسط کشتهای میکروبی رایج بود.
نتایج آزمایشات برای بررسی وجود پنج گونه مهم باکتریایی یعنی ایکولای، اسینتوباکتر، سودوموناس و استاف اورئوس و همچنین عوامل نمایشگر حدت و مقاومت آنتی بیوتیکی سویههای خاص در هر دو رویکرد مشابه بود. اما رویکرد PAD این نتایج را در کمتر از دو ساعت ارائه کرد در حالیکه نتایج کشت باکتریایی بین سه تا پنج روز طول کشید.
این تحقیق در مجله Science Advances منتشر شده است.
منبع: ایسنا

.png)


